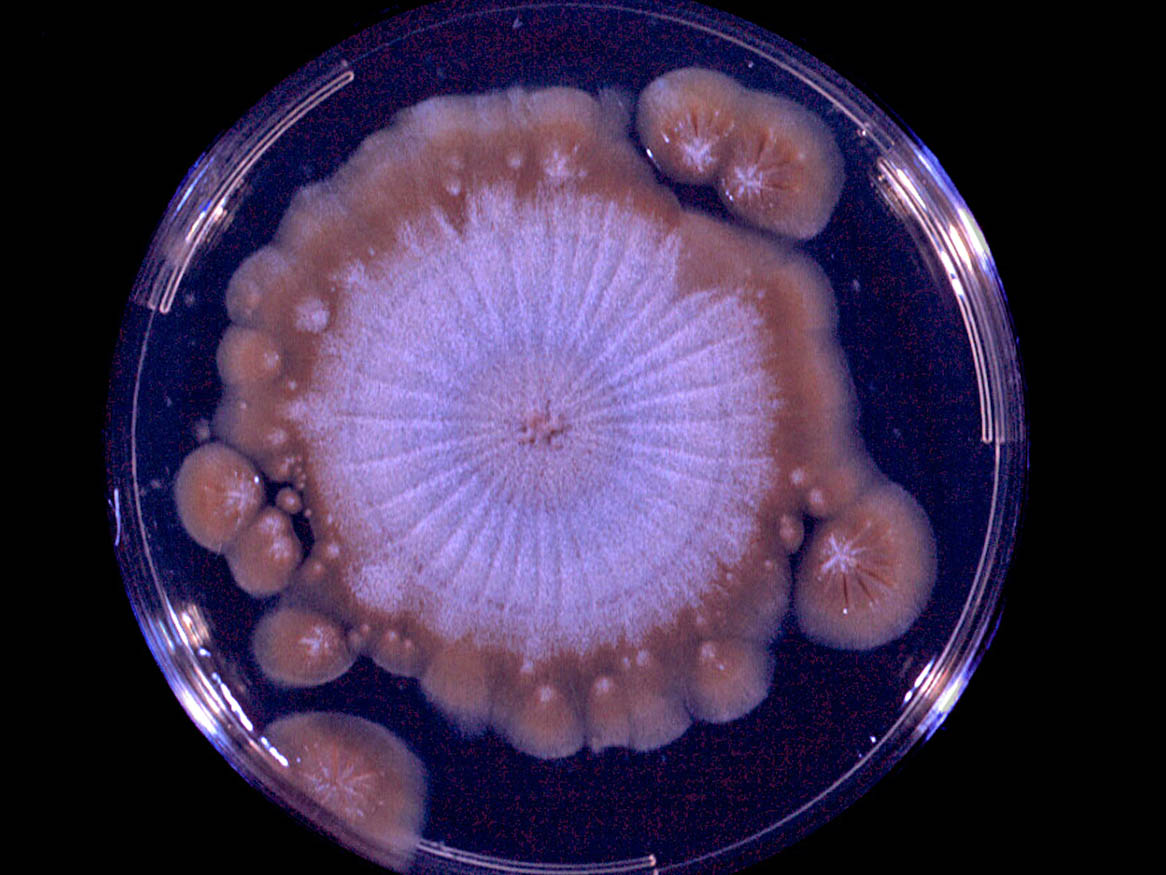
Culture

Status message
Correct! Excellent, you have done well. Please find additional information below.
Unknown 1 = Basidiobolus ranarum
Clinical presentation: Entomophthoromycosis caused by Basidiobolus ranarum showing ulcerated subcutaneous lesions on the abdomen of a young boy from Darwin.

Histopathology: Haematoxylin and eosin (H&E) stained section of tissue showing broad septate hyphae surrounded by an eosinophilic sheath (Splendore-Hoeppli phenomenon) typical of Entomophthoromycosis. Note there are two major histological differences between subcutaneous zygomycosis caused by Basidiobolus and Conidiobolus (Entomophthoromycosis) and zygomycosis caused by members of the Mucorales (mucormycosis). Firstly, in Entomophthoromycosis the hyphae are surrounded by an eosinophilic sheath and there is a lack of vascular invasion, which is so characteristic of infections caused by the Mucorales. Secondly, the hyphal elements of Mucorales are sparsely septate in tissue, whereas frequent septation is seen in tissue hyphae of Basidiobolus or Conidiobolus.

Culture: Basidiobolus ranarum on Sabouraud's dextrose agar after 17 days incubation at 26C showing a flat, yellowish-grey, glabrous, radially folded colony covered by a fine, powdery, white surface mycelium. Note the satellite colonies formed by germinating conidia ejected from the primary colony.
Microscopy: Microscopic morphology of Basidiobolus ranarum showing globose, one-celled conidia that are forcibly discharged from a sporophore. The sporophore has a distinct swollen area just below the spore that actively participates in the discharge of the spore.

Comment: Basidiobolus ranarum is commonly present in decaying fruit and vegetable matter, and as a commensal in the intestinal tract of frogs, toads and lizards. It has been reported from tropical regions of Africa and Asia including India, Indonesia and Australia.
About Basidiobolus Back to virtual assessment



